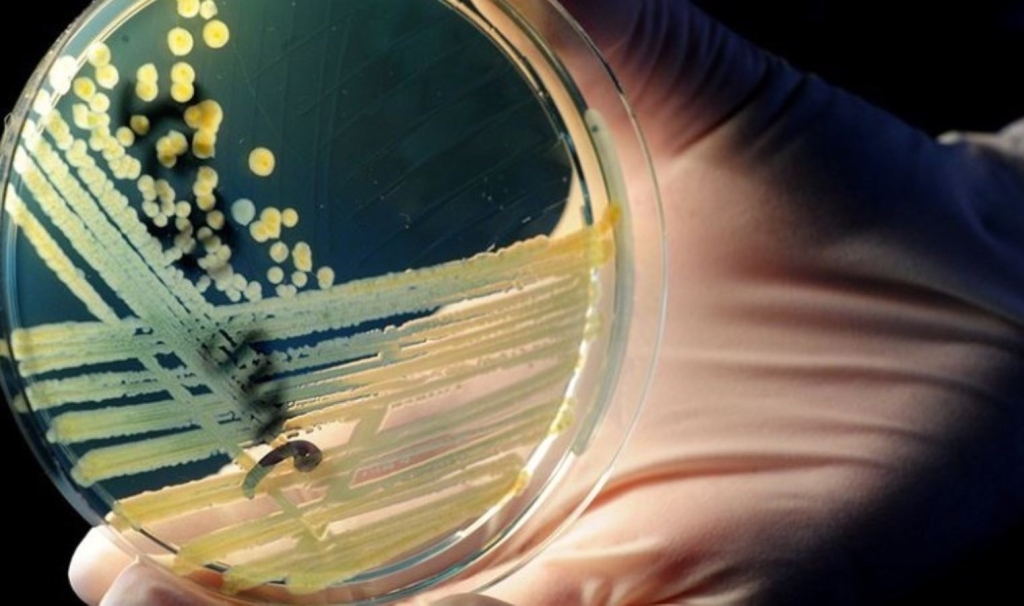
featured

Prof. Dr. Ayazoğlu, Antimikrobiyal direncin dünya genelinde giderek büyüyen bir sıhhat tehdidi olarak karşımıza çıktığını belirtetek, “Mikropların tedavi maksadıyla kullanılan ilaçlara karşı direnç geliştirmesi, enfeksiyonların tedavisini zorlaştırır ve bu durum yalnızca bireyler için değil, tüm insanlık için önemli sonuçlar doğurur. 2019 yılında Antimikrobiyal Direnç nedeniyle yaklaşık 5 milyon insan hayatını kaybetmişken, bu sayının 2025-2050 yılları ortasında 96 milyon bireye ulaşması bekleniyor. AMD’nin en büyük tehdit ettiği alanlardan biri ise, hayati tehlike taşıyan hastaların tedavi gördüğü ağır bakım üniteleridir” dedi.
YOĞUN BAKIMDA ANTİMİKROBİYAL DİRENCİN ARTAN TEHDİDİ
Prof. Dr. Ayazoğlu açıklamanın devamında, “Yoğun bakım üniteleri, ağır hastalıkları nedeniyle ömür uğraşı veren hastaların tedavi edildiği kritik alanlardır. Bu ünitelerdeki hastalar, bağışıklık sistemlerinin zayıf olması, uzun müddetli hastanede kalış, invaziv tıbbi aygıtların kullanımı ve sıkça antibiyotik reçetesi yazılması üzere bir dizi faktörle enfeksiyonlara karşı daha savunmasızdır. Bu durum, antimikrobiyal direnç gelişimini hızlandırarak tedavi sürecini daha da karmaşık hale getirir. İnvaziv aygıtlar, bilhassa ventilatörler (solunum cihazları), kateterler ve damar içi çizgiler üzere tıbbi araçlar, mikropların bedene girişine taban hazırlar. Örneğin, ventilatörle alakalı pnömoni (VAP), ağır bakımda sıkça görülen ve dirençli mikropların süratle yayılmasına yol açan bir enfeksiyondur. Ağır bakım hastalarında yaygın olarak kullanılan geniş spektrumlu antibiyotikler, bedendeki yararlı mikropları da öldürerek dirençli mikropların çoğalmasına fırsat tanır” dedi.
Antimikrobiyal direncin ağır bakımda yol açtığı problemleri sıralayan Prof. Dr. Ayazoğlu, Yoğun bakım ünitelerinde AMD, önemli problemlere yol açmaktadır. Bu problemler, yalnızca hasta sıhhatini değil, tıpkı vakitte sıhhat sistemlerini de olumsuz tesirleri sıraladı. Prof. Dr. Ayazoğlu,
“1. Tedavi Edilemeyen Enfeksiyonlar: AMD’li mikroplar tarafından oluşturulan enfeksiyonlar, klâsik antibiyotiklerle tedavi edilemez. Bu da tedavi sürecini zorlaştırır, hastaların düzgünleşmesini geciktirir ve bazen ölümcül sonuçlar doğurur. Ağır bakım hastalarındaki dirençli enfeksiyonlar, tedaviye karşılık vermediği için mevt oranlarını artırabilir.
2. Hastanede Kalış Mühletinin Uzaması: Dirençli enfeksiyonlar, hastaların hastanede kalış müddetlerini uzatır. Bu, hem hastalar için daha fazla acıya yol açar hem de sıhhat sistemi için ek maliyetler getirir. Uzun periyodik hastanede kalış, mikropların yayılma riskini artırır.
3. Hasta Vefat Oranlarının Artması: Ağır bakımda AMD’in en korkutucu yanlarından biri, dirençli enfeksiyonların hastaların mevt oranlarını artırmasıdır. Bağışıklık sistemi zayıflamış hastalarda, kolay bir enfeksiyon bile ölümcül olabilir. Antimikrobiyal direncin yaygınlaşması, daha evvel tedavi edilebilen hastalıkların, ölümcül hale gelmesine neden olabilir.
4. Dirençli “Süperböceklerin” Yayılması: Ağır bakım ünitelerinde dirençli mikropların yayılması, “süperböcekler” olarak bilinen çoklu ilaçlara dirençli mikropların ortaya çıkmasına yol açabilir. Bu mikroplar, birden fazla antibiyotikten etkilenmedikleri için tedavi edilmesi son derece güç hale gelir ve bu da sıhhat sistemleri için büyük bir tehdit oluşturur.
Dünya Sıhhat Örgütü (WHO), antimikrobiyal direncin sıhhat sistemlerini tehdit eden en büyük tehlikelerden biri olduğunu vurgulamaktadır. Bu, birtakım enfeksiyonların tedavi edilemez hale gelmesine yol açabilir ve yaygın antibiyotiklerin etkisiz hale gelmesiyle, kolay enfeksiyonlar bile ölümcül olabilir” halinde sıraladı.
ANTİMİKROBİYAL DİRENCİN NEDENLERİ
Antimikrobiyal direnç, birçok faktörle hızlanabileceğini açıklayan Prof. Dr. Ayazoğlu, “Bunlar ortasında: 1. Antibiyotiklerin Gereksiz Kullanımı: Soğuk algınlığı ve grip üzere virüs kaynaklı hastalıkların tedavisinde antibiyotiklerin gereksiz yere kullanılması, direnç gelişimini hızlandırır. Antibiyotikler yalnızca bakteriyel enfeksiyonları tedavi eder; virüsler üzerinde tesirli değildir.
2. Antibiyotiklerin Çok Kullanımı: Antibiyotiklerin yanlış dozda yahut müddette kullanılması, mikropların bu ilaçlara karşı direnç geliştirmesini sağlar. Ayrıyeten, veterinerlik alanında hayvanlara verilen antibiyotikler de direnç gelişimine yol açabilir.
3. Seyahat ve Global Ticaret: Global seyahat ve ticaret, dirençli mikropların süratle farklı bölgelere yayılmasına imkan tanır. Bir ülkede gelişen dirençli enfeksiyonlar, süratle diğer bir ülkeye taşınabilir” olacağını belirtti.
ANTİMİKROBİYAL DİRENÇ NASIL ÖNLENİR?
Antimikrobiyal direnç, hem bireylerin hem de sıhhat hizmeti sağlayıcılarının alacağı kimi kolay ancak tesirli tedbirlerle azaltılabileceğini açıklayan Prof. Dr. Ayazoğlu, önlemleri şu biçimde sıraladı:
1. Antibiyotik Kullanımını Sınırlamak: Antibiyotikler sırf gerekli durumlarda ve yanlışsız dozda kullanılmalıdır. Antibiyotiklerin sadece bakteriyel enfeksiyonlarda kullanılması gerekir; soğuk algınlığı ve grip üzere virüs enfeksiyonları antibiyotiklerle tedavi edilmez.
2. Hijyen ve Dezenfeksiyon: El yıkama, yüzeylerin nizamlı olarak dezenfekte edilmesi, sıhhat hizmetlerinde mikropların yayılmasını engellemeye yardımcı olur. Sıhhat çalışanları ve hastalar ortasındaki hijyen tedbirleri, mikropların yayılmasını durdurmada kritik rol oynar.
3. Seyahat Sonrası Bilgi Verme: Yakın vakitte diğer bir ülkeye seyahat ettiyseniz yahut o ülkede sıhhat hizmeti aldıysanız, sıhhat uzmanınıza bunu bildirmek değerlidir. Farklı bölgelerdeki antimikrobiyal direnç profilleri farklı olabilir ve bu bilgi, yanlışsız tedavi planının oluşturulmasına yardımcı olur.
4. Erken Teşhis ve Yanlışsız Tedavi: Dirençli enfeksiyonlar erken tespit edildiğinde, tedavi süreci daha tesirli olabilir. Hastalar, hastanelere başvurduklarında sıhhat profesyonelleri, hastalıklarının dirençli olup olmadığını belirlemek için gereken testleri yapmalıdır.
5. Aşılar ve Sağlıklı Alışkanlıklar: Aşılar, mikropların yayılmasını ve enfeksiyonların ortaya çıkmasını engelleyebilir. Ayrıyeten sağlıklı ömür şekli alışkanlıkları, bağışıklık sistemini güçlendirir ve enfeksiyonlardan korunmada yardımcı olur.
6. Karantina ve İzolasyon: Dirençli mikropların salgın yapması durumunda, enfekte hastaların karantinaya alınması ve sıhhat kuruluşlarında ziyaretçilerin taranması, mikropların yayılmasını engellemek için önemlidir” dedi.
GELECEĞİMİZİ KORUMAK SİZİN DE ELİNİZDE
Antimikrobiyal direnç, giderek daha yaygın hale gelen ve insan sıhhati için büyük bir tehdit oluşturan bir sıkıntıdır. Gereksiz başta Antibiotik ve antimikrobiyal kullanımının önüne geçilerek bu tehdit önlenebilir. Hem bireyler hem de sıhhat profesyonelleri, şuurlu davranarak ve gerekli önlemleri alarak dirençli mikropların yayılmasını engelleyebilir. Sıhhat hizmeti sağlayıcılarının dikkatli ve sorumlu bir formda ilaç kullanımı konusunda yönlendirmeleri, toplumda dirençli mikropların yayılmasını önlemede en değerli adımdır.
Unutmayalım ki, Antimikrobiyal direnç, sessiz bir katil üzere ilerliyor. Lakin şuurlu bir toplum ve gerçek adımlar sayesinde bu tehditten korunabiliriz” açıklamasını yaptı.